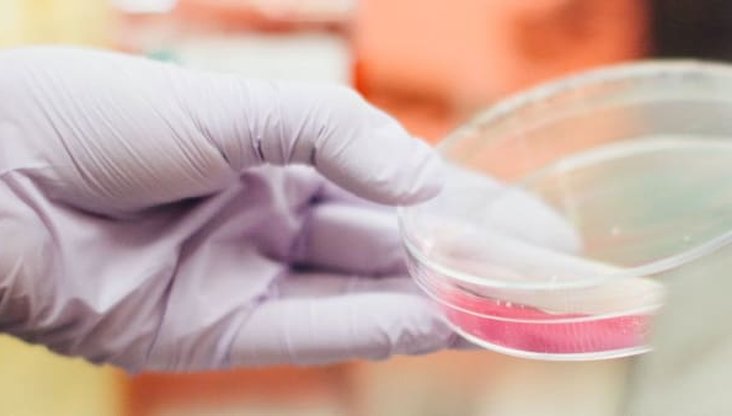
None

Kira Noble, supported by Solving Kids' Cancer throughout her cancer journey, appeared on Scotland Tonight on 13th February as STV followed her latest scan and results.

Solving Kids’ Cancer Europe, Solving Kids' Cancer in New York, Oscar Knox Fund, Smiles for Stanley Fund and Merryn Lacy Trust have awarded a grant of $420,000.

We explain the recent statement from the UK clinical community.

SIOPEN, the UK National Cancer Research Institute Neuroblastoma Group and the CCLG Neuroblastoma Special Interest Group are committed to further improving the outcome for children with neuroblastoma.
This new clinical trial will be available to children in 40 hospitals across 11 European countries and has been jointly funded by Solving Kids’ Cancer UK and the French charity, Imagine for Margo.

Solving Kids' Cancer UK thanks GamesAid – the UK video games industry based charity – for their important and generous support in 2019.

Solving Kids’ Cancer is pleased to announce that it has awarded a grant of £250,000 to Professor John Anderson of UCL, to study preclinical refinements of treatment of neuroblastoma with CAR-T cells.

A team at Newcastle University are carrying out a neuroblastoma study that is being sponsored by Newcastle upon Tyne Hospitals NHS Trust and funded by Action Medical Research.

We are pleased to see many of our own aims included in the new NHS England Long Term Plan, areas we are working so hard on to improve outcomes for children and families affected by neuroblastoma.

